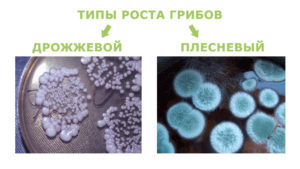
image

Характеристики препарата
Форма выпуска: крем, таблетки
Показания к применению: грибковые поражения кожи, ногтей, системные микозы, лишай
Побочные эффекты: покраснение, зуд, жжение
Противопоказания: беременность, кормление грудью, патологии печени и почек
Цена: крем 250 руб., таблетки 600 руб.
«Тербизил» – высокоэффективное лекарственное средство широкого спектра, направленное на лечение грибковых заболеваний различной локализации. Активное противомикробное вещество универсального спектра действия – тербинафин.
Формы выпуска и состав
В продаже представлены следующие формы препарата – «Тербизил» крем и таблетки. Средства предназначаются для наружного и внутреннего применения соответственно.
На 1 мл крема приходится 10 мг активного вещества тебинафин гидрохлорид. Остальной объем составляют вспомогательные компоненты. Форма продажи – металлическая туба объемом 15 г, картонная упаковка. В состав одной «Тербизил» таблетки входит 125 либо 250 мг тербинафина гидрохлорида (в зависимости от дозировки) и дополнительные компоненты.
Фармакология
Мази и таблетки «Тербизил» оказывают действие на следующие типы грибков:
- дерматофиты;
- диморфы;
- дрожжевые;
- плесневые;
- возбудители лишая.
Выраженный терапевтический эффект заметен в первые дни применения.

Аналоги
Аналогов у «Тербизила» существует много. Самые популярные аналоги «Тербизил» имеет следующие – это «Экзифин», «Тербикс», «Ламикан», «Онихон», «Ламизил». Принцип действия перечисленных лекарственных средств схож.
Показания к использованию
«Тербизил» назначается для лечения:
- Грибковых поражений кожи инфекционного характера, вызванных деятельностью дерматрофитов (это онихомикозы ногтей, микозы кожи головы).
- Инфекционных заболеваний кожи, спровоцированных дрожжеподобными грибковыми микроорганизмами Кандида.
- Микозов различной локализации, развитие которых вызывают микроспоры.
- Системными микозами кожных покровов.
- Разноцветного лишая.
Перед началом использования крема или таблеток прочтите инструкцию по применению. Самолечение нежелательно – обязательно обратитесь к врачу, чтобы он назначил вам именно «Тербизил» (возможно, вам лучше будет использовать другое средство, или потребуется комплексное лечение).
Противопоказания
Крем не рекомендуется применять в случае гиперчувствительности по отношению к основным компонентам. Не следует использовать мазь беременным женщинам и кормящим матерям.
Таблетки «Тербизил» не назначают в случае непереносимости активных веществ, входящих в их состав, во время беременности, лактации, при патологиях печени и почек разного характера. Детям в возрасте до двух лет данный препарат давать нельзя. В случае наличия новообразований, сосудистых патологиях, проблем с метаболизмом, алкоголизме препарат используют, но с осторожностью.
Как применять
Крем наносят на чистую сухую кожу. При заболеваниях туловища и голеней терапия назначается на две недели, наносить крем нужно дважды в день. При микозах стоп мазь нужно использовать дольше – до одного месяца. Чтобы вылечить лишай, достаточно будет наносить мазь до двух раз в день в течение пары недель.
Взрослым, подросткам, пожилым людям таблетки назначаются в дозировке 250 мг (это суточная норма). Курс лечения зависит от тяжести заболевания и состояния пациента.
Важно! Если вы кормите ребенка грудью, грудное вскармливание на время лечения придется прекратить.
Возможные побочные эффекты
Средство может вызывать нежелательные побочные реакции:
- покраснения кожи;
- зуд, жжение кожных покровов;
- тошноту;
- мигрени;
- крапивницу.
Данные проявления являются строго индивидуальными – если у вас начались нежелательные реакции, значит, лечение следует немедленно прекратить. В ряде случаев таблетки «Тербизил» могут вызывать тошноту, неприятные ощущения внизу живота, расстройство желудка. Другие возможные побочные эффекты – отеки, мышечные и суставные боли, выпадение волос, отсутствие аппетита. Изменения в работе вкусовых рецепторов, составе крови, появление желтухи, гепатитов при приеме препарата возможны, но встречаются крайне редко.
Условия хранения
«Тербизил» следует хранить при температуре воздуха от 15 до 30 градусов в защищенном от солнца месте. Крем нужно использовать в течение пяти лет, период хранения таблетированной формы препарата составляет два года.
Дополнительная информация
- По отзывам врачей, нерегулярное использование крема, таблеток «Тербизил» или досрочное завершение терапевтического лечения повышает риски рецидивов.
- Если спустя две недели лечения вы не заметили положительных изменений, нужно провести повторное исследование, направленное на определение возбудителя и его чувствительности к тем или иным противогрибковым средствам.
- В ходе терапии нужно следить за показателями функции печени. В случае дисфункции данного органа препарат следует отменить.
- Отрубевидный лишай лечится строго местно (принимать таблетки нет смысла).
- В процессе лечения и по его завершении следует проводить обработку всей обуви, носков, постельного белья.
- Избегайте попадания мази на слизистые органов.
- Удаление ногтевых пластин, как правило, не требуется.
Цены
Средняя цена крема составляет около 250 рублей. Таблетки 250 мг стоят от 1000 рублей за пачку, 125 мг – от 600 рублей. Таблетированная форма препарата выпускается в упаковках по 14 и 28 штук – стоимость упаковок по 28 штук получается более выгодной для пациента.
Отзывы о препарате
Борис: Очень эффективная и при этом недорогая мазь. Первый раз она мне не помогла, поскольку я прекратил лечение спустя неделю – после облегчения состояния. Когда программу прошел полностью, все симптомы исчезли.
Анна: Лечила «Тербизилом» лишай. Облегчение наступило спустя несколько дней после применения.
Ирина: Мне, к сожалению, препарат не подошел (пила таблетки) – началась тошнота, рвота, появились аллергические пятна на теле. Будьте осторожны!
Частые вопросы
Какие показания к использованию препарата Тербизил?
Препарат Тербизил обычно используется для лечения грибковых инфекций кожи, таких как атлетическая стопа, дерматофитозы и др.
Какие аналоги препарата Тербизил существуют?
Существуют различные аналоги препарата Тербизил, включая препараты на основе тербинафина, кетоконазола и других антимикотических средств.
Как выбрать между препаратом Тербизил и его аналогами?
Выбор между препаратом Тербизил и его аналогами зависит от индивидуальных особенностей пациента, тяжести заболевания, наличия аллергий и других факторов. Важно проконсультироваться с врачом для выбора наиболее подходящего препарата.
Полезные советы
СОВЕТ №1
Перед началом применения препарата Тербизил или его аналогов обязательно проконсультируйтесь с врачом-дерматологом или микологом. Только специалист сможет оценить состояние вашей кожи или ногтей, поставить правильный диагноз и подобрать наиболее эффективное лечение.
СОВЕТ №2
При использовании препарата Тербизил или его аналогов строго соблюдайте рекомендации по дозировке и продолжительности курса лечения, указанные в инструкции к препарату. Не прекращайте прием препарата досрочно, даже если симптомы заболевания исчезли, чтобы избежать рецидива инфекции.
СОВЕТ №3
При возникновении побочных эффектов или аллергических реакций на препарат Тербизил или его аналоги немедленно обратитесь к врачу. Не пытайтесь самостоятельно изменять дозировку или заменять препарат на другой без консультации специалиста.